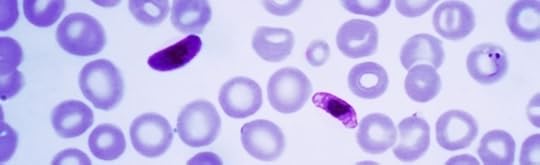

Discovery Institute's Blog, page 228
August 15, 2014
How Many Ways Are There to Win at Sandwalk?

At University of Toronto professor Laurence Moran's blog Sandwalk, named for Darwin's famous "thinking path," I've followed a discussion of the evolution of de novo chloroquine resistance by malaria (which I wrote about here). The exchange has touched on a few issues that seem to confuse people easily.
One is how we should view the probability of winning something. In questioning my malaria numbers, a commenter remarked that it's misleading to focus retrospectively on a single event, such as...
August 14, 2014
Monkey Business at Amazon

Hmm, what's this? We noticed that overnight eight 5-star reviews for Stephen Meyer's book Darwin's Doubt were mysteriously erased. Just vanished. Since these were positive reviews, it is unlikely they were "abusive" which is the normal criterion that Amazon has for removing reviews. Interesting.
These kinds of shenanigans always seem to happen when our critics are feeling maximally pressed because they can't answer our arguments on the merits. They thus see the need to resort to schemes and t...
Simple Fractal Branching Explains the Ediacaran Rangeomorphs

As explained in Stephen Meyer's book Darwin's Doubt, the Ediacaran animals (if they can be called animals at all) bear no evolutionary connection to the complex body plans that "exploded" onto the scene with great profusion in the Cambrian fossil record. That assessment is reinforced by a new analysis of some frond-shaped Ediacarans called Rangeomorphs by Simon Conway Morris and Jennifer H. Hoyal Cuthill in the Proceedings of the National Academy of Sciences.
The take-home message of Conway M...
War on Humans: Suicide Cult Pushes Homemade Suicide Kits
 Suicide advocacy never stops. Even as the world mourns a celebrity self-destruction,Derek Humpry's group ERGO -- Euthanasia Research Guidance Organization -- continues the death proselytizing -- this time pushing a booklet, How to Make Your Own Helium Hood Kit.
Suicide advocacy never stops. Even as the world mourns a celebrity self-destruction,Derek Humpry's group ERGO -- Euthanasia Research Guidance Organization -- continues the death proselytizing -- this time pushing a booklet, How to Make Your Own Helium Hood Kit.
Humphry lives in Oregon, by the way. Legalization of assisted suicide does not stop suicide advocacy outside of a law's legal parameters. It never will.
But Wesley, Humphry is a social outlaw! He's not part of the mainstream of assisted...
August 13, 2014
Dembski Speaks at the University of Chicago; Mathematician Leo Kadanoff Says Darwinists Need to "Deal with These Questions"


Discovery Institute's Dr. William Dembski spoke at the University of Chicago today on "Conservation of Information [CoI] in Evolutionary Search," arguing that "CoI has implications for teleology in nature, consistent with natural teleological laws mooted in Thomas Nagel's Mind & Cosmos." The event was under the auspices of the university's Computations in Science Seminars.
The talk itself and the Q&A afterward, which were at a pretty high level, went very well. There were no disruptions, and...
"Boy, You Are Insane!" "No, I'm Just Evolved."

My wife Debra and I have been enjoying the new TNT television crime drama Murder in the First. The other night, the villain articulated his value system -- and it is pure anti-human exceptionalism.
POSSIBLE SPOILER ALERT for those who haven't seen the program or the final episode yet.
The villain admits to a friend that he killed his pregnant girl friend. (I will not name the characters.) From the script:
Friend: She was carrying your child!
Villain:She was carrying a fetus. I told her to get...
Laurence Moran's Sandwalk Evolves Chloroquine Resistance
First, a bit of background. As I discussed previously (see here, here, and here) in a new paper Summers et al. show that a minimum of two mutations to the malarial protein PfCRT are needed to confer an ability to pump the antibiotic chloroquine (which is necessary but may not be sufficient for chloroquine resistance in the wild).
That result agrees with my discussion in The Edge of Evolution and goes a long way toward quantitatively explaining the rarity of the development of resistance. Ove...
In Case You Were Wondering What Steve Meyer's Signature in the Cell Looks Like in Korean


Here it is. A gentleman from Korea visiting Seattle and the Pacific Northwest popped by the office with his copy, seeking Dr. Meyer's own signature on his copy of Signature in the Cell: DNA and the Evidence for Intelligent Design.
Photo credit: Jens Jorgenson.
August 12, 2014
Cladistics Made Easy: Why an Arcane Field of Study Fails to Upset Steve Meyer's Argument for Intelligent Design
Enjoy this remarkably clear and amusing conversation with Stephen Meyer about, first of all, what cladistics is and second, why this method of classification analysis in biology leaves the argument in Darwin's Doubt unscathed. That's despite claims to the contrary in Nick Matzke's review of the book that many Darwinists initially cited as the definitive response to Meyer.
On Robin Williams's Death, a Revealing Dispute Between Atheist-Evolutionist Spokesmen
At Why Evolution Is True, evolutionary atheist Jerry Coyne is disgusted -- rightly -- by comments from his evolutionary atheist colleague PZ Myers on Robin Williams's tragic suicide. Writing at Pharyngula, Myers seems to think Williams's death is noteworthy not as a source of heartbreak for millions who loved his art, but as a suspiciously convenient distraction from racial violence in St. Louis.
Says Professor Coyne:
This is one of the most contemptible and inhumane things I've ever seen pos...
Discovery Institute's Blog
- Discovery Institute's profile
- 15 followers